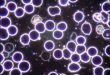

Sterie Ciumetti | Localnicii din Ditrău au făcut blitzkrieg.
Read More »Dacă ești nou pe site, această rubrică este un punct de inițiere.
Adevărul este descoperirea continuă, bunul cel mai de seamă care poate fi dobândit, el trebuie permanent meritat.
Cine caută Adevărul trebuie să știe un lucru teribil... într-o zi, va sfârși prin a-l găsi. Este el pregătit să plătească prețul, să suporte acest Adevăr?
-
Știrea Săptămânii: Florin Cîțu îl demite, noaptea ca hoții, pe Octav Bjoza, președintele Asociației Foștilor Deținuți Politici, pentru ‘reducerea dimensiunii holocaustului’
-
Multiculturalism în România – Viol, Crimă și Incendiu în Capitală
-
Ce Este Planul Kalergi și De Ce Este Relevant
-
Adevărul Despre Revoluție
-
Planul Kalergi si Noua Ordine Mondială
-
INTERVIU INCENDIAR cu Doamna Profesoară Iulia Radulescu
-
Evreul Petre Roman: “Sunt bucureștean get-beget”
-
Cine a Tras (De Fapt) În Noi?
-
EXPLOZIV ȘI EXCLUSIV: Interviul INTERZIS în Presa Românească
-
România, azi
-
Cine e în Spatele Proiectului Roșia Montană
-
Ce Este Agenda Homosexuală si Mișcarea LGBTQpedo
-
Nu am tras primul, ci ultimul!
-
EXPLOZIV! Ultimul Interviu cu autorul Mihai Șerban
-
Rabin Dizident Confirmă Adevărul Despre Talmud “ucide-l pe cel mai bun dintre ne-evrei!”
-
Activismul din România, #rezist, Portrete de „Tefeliști” (Tineretul Frumos și Liber) de Profesie „Mitingiști” (II)
-
Interviu EXPLOZIV cu doctorul TEODOR USCA
-
Microzimele – Taina Vieții (I)
-
DEȘERTĂCIUNE?! Nu, APĂRARE!
-
Barbarul ritual al tăierii împrejur
-
Organizația ANTIFA, de la Origini Până la Soroș
-
Dialog cu profesorul Corvin Lupu. Opinii despre România sub presiunea virușilor și despre noua conducere de la Washington (III)
-
Cum s-a Bucurat Suedia de Progresism și Multiculturalism în 2018
-
Cum îți Programează (((Hollywood))) Mintea – Partea a II-a
-
Adevărata Semnificație a Mioriței – Baciul eticii populare românești
-
Cum funcționează Activismul (I)
-
ÎN PLINĂ PANDEMIE Klaus Iohannis Majorează Salariul pentru Activiști Neomarxiști
-
Vizita Papei – Autonomie Alternativă
-
Am luat interviu unor elevi despre Holocaust
Puneți-vă întrebări, gândiți pe cont propriu, nu ne credeți pe cuvânt cu privire la ceea ce scriem, cercetați, căutați permanent adevărul, revizuiți.
Incorect Politic O Publicație Dizidentă